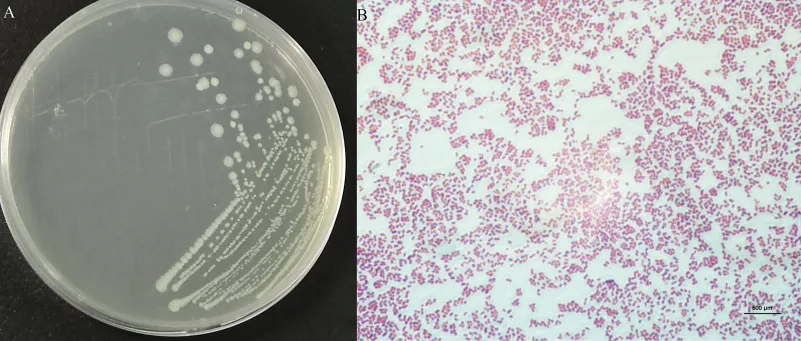
Morganella: objawy i metody leczenia tej niebezpiecznej bakterii.

Morganella morganii to bakteria Gram-ujemna występująca naturalnie w przewodzie pokarmowym ludzi i zwierząt. Należy do rodziny Enterobacteriaceae i może stanowić poważne zagrożenie dla zdrowia, szczególnie u osób z obniżoną odpornością. Bakteria ta została odkryta w 1906 roku przez brytyjskiego naukowca H. de R. Morgana.
Choć zwykle nie powoduje problemów u zdrowych osób, M. morganii może wywoływać groźne zakażenia szpitalne. Najczęściej atakuje drogi moczowe, rany pooperacyjne i może prowadzić do sepsy. Szczególnie niebezpieczna jest jej zdolność do oporności na wiele antybiotyków.
Najważniejsze informacje:- Naturalna bakteria układu pokarmowego, która może stać się groźnym patogenem
- Szczególnie niebezpieczna dla osób z osłabionym układem odpornościowym
- Wywołuje głównie zakażenia szpitalne
- Często wykazuje oporność na antybiotyki
- Może powodować poważne powikłania, włącznie z sepsą
- Wymaga szybkiej diagnostyki i odpowiedniego leczenia
Czym jest bakteria Morganella morganii?
Morganella morganii należy do rodziny enterobakterii i jest klasyfikowana jako bakteria Gram-ujemna. Ten mikroorganizm ma kształt pałeczki i może przeżyć zarówno w warunkach tlenowych, jak i beztlenowych. Jest powszechnie uznawana za patogen oportunistyczny, co oznacza, że staje się groźna głównie dla osób z osłabioną odpornością.
Morganella posiada zdolność do rozkładu mocznika i wytwarzania enzymów rozkładających różne związki organiczne. Bakteria ta ma niezwykłą zdolność do szybkiego namnażania się w sprzyjających warunkach. Jest również odporna na wiele powszechnie stosowanych antybiotyków.
Ta interesująca bakteria została odkryta w 1906 roku przez brytyjskiego bakteriologa H. de R. Morgana. Od jego nazwiska pochodzi nazwa tego drobnoustroju.
Gdzie najczęściej występuje Morganella?
Morganella naturalnie bytuje w przewodzie pokarmowym ludzi i zwierząt. Można ją znaleźć również w środowisku naturalnym, szczególnie w glebie i wodzie. W warunkach szpitalnych często kolonizuje sprzęt medyczny.
- Przewód pokarmowy (głównie jelito grube)
- Drogi moczowe
- Rany pooperacyjne
- Skóra w okolicach cewników
- Okolice ran i oparzeń
Bakteria przenosi się głównie poprzez kontakt z zakażonym materiałem biologicznym. Zakażenia szpitalne są najczęstszą drogą transmisji.
Czytaj więcej: Odkrycia w biotechnologii: Jak nowe technologie pomagają w leczeniu chorób?
Kto jest najbardziej narażony na zakażenie?
Największe ryzyko zakażenia dotyczy pacjentów z obniżoną odpornością i osób hospitalizowanych. Szczególnie narażone są osoby po zabiegach chirurgicznych i długotrwałej antybiotykoterapii.
Drugą istotną grupę ryzyka stanowią osoby starsze oraz pacjenci z chorobami przewlekłymi. Noworodki i wcześniaki również znajdują się w grupie podwyższonego ryzyka.
Jakie zakażenia wywołuje Morganella morganii?
Morganella może wywoływać różnorodne zakażenia szpitalne. Najczęściej spotykane są infekcje układu moczowego. Bakteria ta może również prowadzić do poważnych powikłań ogólnoustrojowych.
| Rodzaj zakażenia | Objawy | Częstość występowania | Powikłania |
| Infekcje układu moczowego | Dysuria, gorączka, ból | 45% | Niewydolność nerek |
| Zakażenia ran | Stan zapalny, wysięk | 30% | Martwica tkanek |
| Sepsa | Wysoka gorączka, wstrząs | 15% | Niewydolność wielonarządowa |
| Zapalenie płuc | Duszność, kaszel | 10% | Niewydolność oddechowa |
Najpoważniejsze przypadki zakażeń Morganellą dotyczą sepsy. W tej sytuacji śmiertelność może sięgać nawet 50% przypadków.
Rozpoznanie i diagnostyka zakażenia
Diagnostyka rozpoczyna się od wywiadu lekarskiego i badania fizykalnego. Kluczowe jest ustalenie potencjalnego źródła zakażenia. Lekarz zwraca szczególną uwagę na obecność czynników ryzyka.
Następnym krokiem jest pobranie odpowiednich próbek do badań mikrobiologicznych. W przypadku podejrzenia sepsy pobiera się posiewy krwi. Czasami konieczne jest wykonanie badań obrazowych.
Laboratoryjnie Morganella jest identyfikowana poprzez posiew i antybiogram. Test na obecność beta-laktamaz jest kluczowy dla wyboru antybiotyku.
Charakterystyczne objawy zakażenia Morganella
Pierwsze oznaki zakażenia często przypominają grypę. Pacjent może odczuwać ogólne osłabienie i gorączkę. Specyficzne objawy zależą od miejsca infekcji.
- Gorączka powyżej 38.5°C
- Silny ból w miejscu zakażenia
- Zaczerwienienie i obrzęk
- Problemy z oddawaniem moczu
- Wysięk z ran
- Złe samopoczucie i osłabienie
Objawami alarmowymi są spadek ciśnienia krwi i zaburzenia świadomości. W takiej sytuacji konieczna jest natychmiastowa hospitalizacja.
Leczenie zakażeń Morganella
Podstawą leczenia jest odpowiednio dobrana antybiotykoterapia, często stosowana dożylnie. Wybór antybiotyku musi być oparty na wyniku antybiogramu. Morganella często wykazuje oporność na wiele podstawowych antybiotyków.
W ciężkich przypadkach konieczne jest leczenie skojarzone dwoma lub trzema antybiotykami. Bardzo ważne jest również leczenie wspomagające, takie jak nawadnianie i wyrównywanie zaburzeń elektrolitowych. Czasami niezbędne jest chirurgiczne oczyszczenie ogniska zakażenia.
Standardowa terapia trwa od 7 do 14 dni. W przypadku powikłanych zakażeń może być konieczne wydłużenie leczenia do 3-4 tygodni.
Problem antybiotykooporności
Morganella wytwarza enzymy beta-laktamazy, które rozkładają antybiotyki beta-laktamowe. Bakteria ta często posiada również inne mechanizmy oporności. Szczególnie niepokojący jest wzrost liczby szczepów wieloopornych.
| Antybiotyki skuteczne | Antybiotyki nieskuteczne |
| Karbapenemy | Ampicylina |
| Aminoglikozydy | Amoksycylina |
| Fluorochinolony | Cefalosporyny I generacji |
Narastająca oporność Morganelli znacząco ogranicza możliwości terapeutyczne. Prowadzi to do wydłużenia czasu leczenia i zwiększenia jego kosztów.
Zapobieganie zakażeniom szpitalnym
Kluczowe jest przestrzeganie zasad aseptyki i antyseptyki. Personel medyczny musi stosować środki ochrony osobistej. Regularna dezynfekcja sprzętu medycznego jest absolutnie niezbędna.
Izolacja pacjentów zakażonych Morganellą pomaga zapobiec rozprzestrzenianiu się bakterii. Bardzo ważne jest też właściwe postępowanie z odpadami medycznymi. Monitorowanie występowania szczepów opornych pozwala na szybką reakcję.
Przestrzeganie zasad higieny osobistej jest podstawą profilaktyki. Szczególnie istotne jest dokładne mycie rąk.
Powikłania nieleczonych zakażeń
Nieleczone zakażenie Morganellą może prowadzić do sepsy. Jest to stan bezpośredniego zagrożenia życia.
W przypadku infekcji układu moczowego może dojść do uszkodzenia nerek. Możliwe jest też powstanie ropni w różnych narządach.
Zakażenia ran mogą skutkować martwicą tkanek. W skrajnych przypadkach konieczna jest amputacja kończyny.
Śmiertelność w przypadku ciężkich zakażeń Morganellą sięga 30%. W przypadku sepsy wskaźnik ten wzrasta do 50%.
Co powinieneś wiedzieć o zakażeniach Morganellą?
Morganella morganii to groźna bakteria Gram-ujemna, która stanowi szczególne zagrożenie dla osób z obniżoną odpornością. Najczęściej wywołuje zakażenia szpitalne, zwłaszcza infekcje układu moczowego, zakażenia ran i sepsę. Szybka diagnostyka i właściwe leczenie są kluczowe dla powodzenia terapii.
Największym wyzwaniem w leczeniu zakażeń Morganellą jest jej zdolność do wytwarzania beta-laktamaz i rozwój oporności na antybiotyki. Skuteczna terapia wymaga często zastosowania kombinacji kilku antybiotyków i może trwać nawet do 4 tygodni. W przypadku nieleczonych zakażeń śmiertelność może sięgać 50%.
Profilaktyka zakażeń jest równie ważna jak samo leczenie. Przestrzeganie zasad higieny, właściwa dezynfekcja sprzętu medycznego i izolacja zakażonych pacjentów to podstawowe działania zapobiegawcze. Osoby z grup ryzyka powinny zachować szczególną czujność i natychmiast reagować na pierwsze objawy infekcji.